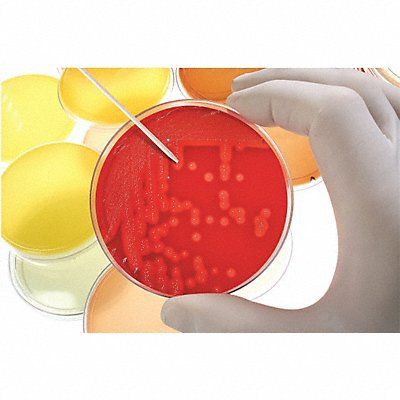

| Item Reference | 24EN48 |
|---|---|
| Brand | HEATHROW SCIENTIFIC |
| Weight (lb) | 3.94 |
| Length (in) | 27.15 |
| Width (in) | 10 |
| Height (in) | 4.25 |
| Harmonization Code | 3926909910 |
| Country of Origin | China |
Item Test Tube Rack Material Polypropylene Blue Height 4 1/4 in Length 27 5/32 in Width 10 in For Use With Test Tubes
Write Your Own Review